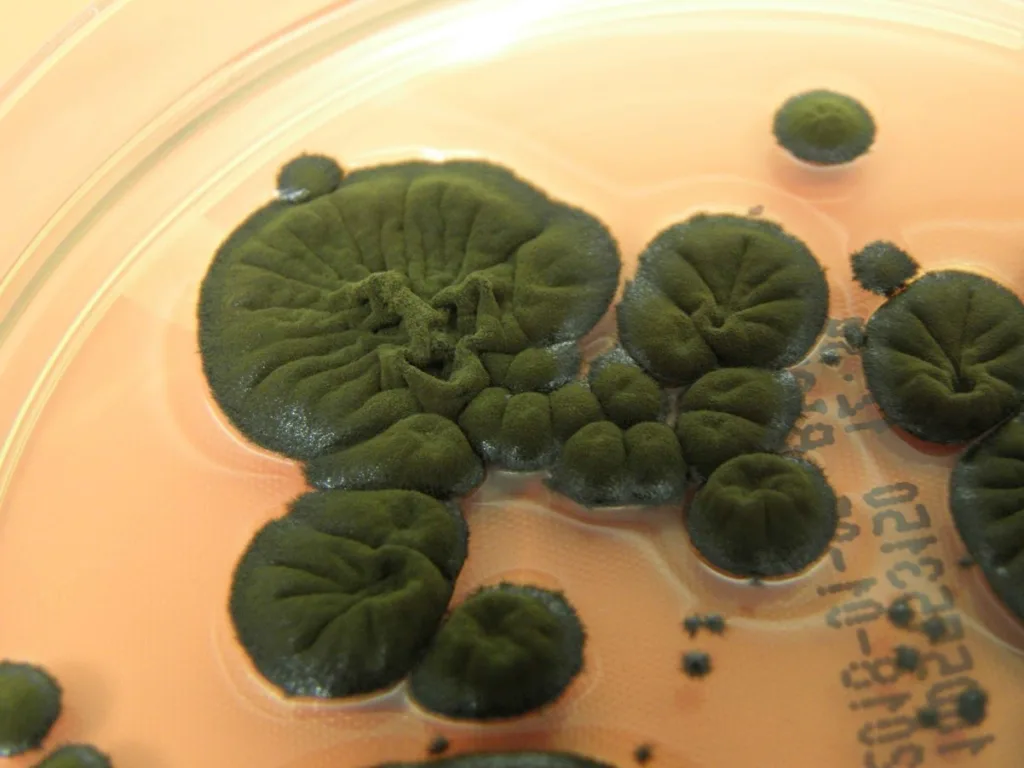

كتب – باسل يوسف:
قبل نحو 40 عامًا، انفجرت محطة تشيرنوبيل للطاقة النووية في روسيا، وطوال تلك السنوات كانت المنطقة محظورة على البشر، لكن المثير أن أشكالا أخرى من الحياة استطاعت التكيف والازدهار.
ربما يرجع جزء من ذلك يعود إلى غياب البشر.. لكن كائنا صغيرا استطاع الاستفادة من الإشعاع المتبقي داخل الهياكل المحيطة بالمفاعل.
وجد العلماء فطرًا أسود غريبًا، متشبثًا بالجدران الداخلية لأحد أكثر المباني إشعاعًا على وجه الأرض، ويعيش أفضل فترات حياته بشكلٍ مثيرٍ للدهشة.
يُطلق على هذا الفطر اسم Cladosporium sphaerospermum، ويعتقد علماء أن صبغته الداكنة – الميلانين – قد تسمح له بتسخير الإشعاع المؤين من خلال عمليةٍ تُشبه الطريقة التي تُسخّر بها النباتات الضوء لعملية التمثيل الضوئي، هذه الآلية المقترحة تُعرف باسم التمثيل الإشعاعي.
بدأ اللغز في أواخر التسعينيات، عندما شرع فريق بقيادة عالمة الأحياء الدقيقة نيلي جدانوفا من الأكاديمية الوطنية الأوكرانية للعلوم في مسح ميداني في منطقة تشيرنوبيل المحظورة لاكتشاف أي نوع من الحياة. وصُدموا بالعثور على مجتمع كامل من الفطريات، يوثق 37 نوعًا مذهلًا.
سيطر فطر C. sphaerospermum على العينات، مع إظهاره أيضًا بعضًا من أعلى مستويات التلوث الإشعاعي.
على الرغم من دهشة الاكتشاف، إلا أن ما حدث لاحقًا زاد من غموضه.
قادت عالمة الأدوية الإشعاعية إيكاترينا داداتشوفا وعالم المناعة أرتورو كاساديفال – وكلاهما يعمل في كلية ألبرت أينشتاين للطب في الولايات المتحدة – فريقًا من العلماء الذين وجدوا أن تعريض فطر C. sphaerospermum للإشعاع المؤين لا يضر الفطر كما يضر الكائنات الحية الأخرى.
الإشعاع المؤين هو انبعاثات جسيمات قوية بما يكفي لطرد الإلكترونات من ذراتها، وتحويلها إلى أشكالها الأيونية.
يبدو هذا الأمر حميدًا نظريًا، ولكن عمليًا، يمكن للتأين أن يُفكك الجزيئات، ويتداخل مع التفاعلات الكيميائية الحيوية، وقد يؤدي إلى تمزيق الحمض النووي. لا يُعد أي من ذلك مفيدًا للإنسان، على الرغم من إمكانية استغلاله لتدمير الخلايا السرطانية، وهي أكثر عرضة لتأثيراته.
ومع ذلك، بدت فطريات C. sphaerospermum مقاومةً بشكلٍ غريب، بل إنها نمت بشكلٍ أفضل عند تعريضها للإشعاع المؤين. وأظهرت تجارب أخرى أن الإشعاع المؤين غيّر سلوك الميلانين الفطري، وهي ملاحظةٌ مثيرةٌ للاهتمام استلزمت مزيدًا من البحث.
وكانت الورقة البحثية اللاحقة التي نشرها داداشوفا وكاساديفال عام 2008 هي التي اقترحا فيها لأول مرة مسارًا بيولوجيًا مشابهًا لعملية التمثيل الضوئي.
يبدو أن الفطر – وأنواعًا أخرى مثله – يحصد الإشعاع المؤين ويحوّله إلى طاقة، حيث يؤدي الميلانين وظيفةً مشابهةً لصبغة الكلوروفيل الممتصة للضوء.
وفي الوقت نفسه، يعمل الميلانين كدرعٍ واق من الآثار الأكثر ضررًا لذلك الإشعاع.
هذه النتائج مدعومة بنتائج بحث نُشر عام 2022، يصف فيه العلماء نتائج نقل فطر C. sphaerospermum إلى الفضاء وربطه بالجزء الخارجي من محطة الفضاء الدولية، ما يعني تعرضه لأقصى قدر من الإشعاع الكوني.
لم يكن الهدف من هذا البحث إثبات أو دراسة عملية التخليق الإشعاعي، بل استكشاف إمكانات الفطر كدرع إشعاعي للرحلات الفضائية، وهي فكرة رائعة. ولكن حتى تاريخ نشر هذا البحث، ما زلنا لا نعرف ما يفعله الفطر فعليًا.
فكرة التخليق الإشعاعي، أشبه بفيلم من الخيال العلمي. ولكن ربما يكون الأروع من ذلك أن هذا الفطر الغريب يقوم بشيء لا نفهمه لتحييد شيء خطير للغاية على البشر.
وليس هذا النوع الوحيد. تُظهر خميرة سوداء، تسمى Wangiella dermatitidis، نموًا مُعززًا تحت الإشعاع المؤين. في الوقت نفسه، يُظهر نوع آخر من الفطريات، Cladosporium cladosporioides، إنتاجًا مُعززًا للميلانين، ولكن ليس نموًا تحت أشعة جاما أو الأشعة فوق البنفسجية.
لذا، فإن السلوك المُلاحظ في C. sphaerospermum ليس شائعًا بين الفطريات المُصطبغة.
هل يشير هذا إلى أنه تكيف يسمح للفطر بالتغذي على ضوء قوي قادر على قتل كائنات حية أخرى؟ أم أنه استجابة إجهادية تعزز البقاء في ظل ظروف مُخففة، وإن لم تكن مثالية؟
ما نعرفه أن هذا الفطر المتواضع يقوم بمهمة ذكية باستخدام الإشعاع المؤين للبقاء على قيد الحياة، وربما حتى التكاثر في مكان خطير للغاية بحيث لا يستطيع البشر الوصول إليه بأمان؛ وأن الحياة، بالفعل، تجد طريقها.
المصدر: livescience
اقرأ أيضا: